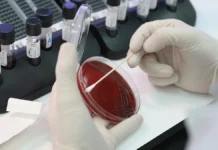
СПбПУ, Гамалеи и Шипиловских сделали прорыв в борьбе с меланомой spbpu gamalei i shipilovskih sdelali proryv v borbe s melanomoj-news-blog-ru-0

Прорывное открытие южнокорейских ученых в лечении онкологии

Группа талантливых исследователей из Национального университета Кёнбук совершила впечатляющий прорыв в области лечения немелкоклеточного рака легких (НМРЛ). Инновационный метод основан на ингаляционной терапии с применением уникальных белковых наночастиц, вдохновленных удивительными свойствами морских мидий.
Немелкоклеточный рак легких представляет собой серьезную медицинскую проблему, составляя целых 85% случаев злокачественных новообразований легких. Главная сложность в борьбе с этим заболеванием заключается в поздней диагностике. Традиционные методы лечения, основанные на внутривенном введении препаратов, зачастую сопровождаются нежелательными побочными эффектами из-за их системного воздействия на организм.
Хотя ингаляционная терапия казалась многообещающим решением, ее применение сталкивалось с определенными ограничениями. Защитные механизмы дыхательной системы, включая слизистую оболочку и иммунные клетки, существенно снижали результативность такого подхода.
Вдохновившись природными механизмами, исследовательская команда обратила внимание на удивительную способность морских мидий создавать прочные связи с различными поверхностями даже в водной среде. Этот феномен лег в основу разработки инновационного решения.
В результате кропотливой работы ученым удалось создать революционный белок fp-1, обладающий усиленными адгезивными характеристиками. Этот биоматериал открывает новые горизонты в targeted-терапии онкологических заболеваний.
Результаты лабораторных исследований превзошли самые смелые ожидания. Разработанные наночастицы, доставляемые в легкие с помощью современного небулайзера, продемонстрировали высокую эффективность в борьбе с раковыми клетками. Благодаря способности длительное время удерживаться на слизистой оболочке, они успешно подавляют процессы метастазирования и распространения злокачественных образований.
Эта инновационная разработка представляет собой значительный шаг вперед в онкологии, открывая новые перспективы для пациентов с диагнозом НМРЛ. Параллельно с этим медицинское сообщество достигло успехов и в лечении других форм рака – например, в терапии рака предстательной железы с использованием водяного пара.
Источник: www.gazeta.ru